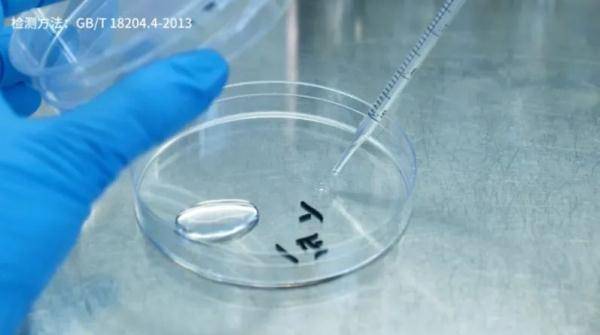

最近一段时间
共享充电宝的价格问题
成为不少网友的吐槽热点
↓↓↓
共享充电宝价格暴涨近5倍
离不开又“用不起”
但是大家有没有想过
经常使用的共享充电宝
它的卫生状况又是如何呢?

文章图片
大家见过有人给充电宝们消毒么?
它们的表面细菌是不是也被共享了呢?

文章图片
【怪兽|共享充电宝有多脏?比马桶还脏五倍多!?】共享充电宝有多脏?
为了回答这个问题 , 采访人员购买了怪兽充电、小电、街电三家的充电宝 。

文章图片
为避免造成二次污染 , 送测之前 , 根据操作手册 , 严格密封保存上述三款共享充电宝 , 并在当天就送到了微生物实验室 ,检测一下这些共享充电宝到底有多脏?谁最脏?

文章图片

文章图片
根据《公共场所卫生检验方法国家标准》 , 对三款充电宝的正反面分别进行了取样、稀释 , 之后加入营养琼脂培养基 , 等待培养基凝固之后 , 在培养箱中以37度恒温倒置培养48小时 。

文章图片
文章图片
菌落总数实验的结果显示:怪兽充电宝相对比较干净 , 应该还是定期做过清洁消毒的 。
怪兽充电宝:每平米菌落总数8000CFU;
街电充电宝:每平米菌落总数21.6万CFU;
小电充电宝:每平米菌落总数44万CFU 。

文章图片

文章图片
一般来讲 , 马桶的表面菌落总数通常在每平米8万CFU左右;如此看来 , 小电和街电的外表面确实比马桶细菌更多 。

文章图片

文章图片
实验室的研究员表示 , 平时测试酒店的毛巾 , 清洁做的比较差 , 一般菌落数也就在每平米几万CFU的水平 。

文章图片
不过 , 大家也不用过分担心
在日常生活中
接触细菌是不可避免的
关键在于自己勤洗手勤消毒
每次取完充电宝用酒精湿巾擦一擦
或者多洗几次手
就能很有效的杀灭细菌
当然 , 要是一边拿着充电
一边吃饭……
那后果可想而知咯!

文章图片
来源|新闻坊、凰家评测、凤凰网科技、凤凰新闻客户端
[责任编辑: ]
推荐阅读
- 硬件|闪极140W多口充电器发布:首发399元 支持PD3.1
- 底仓|联想 YOGA M5 无线鼠标开卖:金属上盖 / USB-C 充电,首发 99 元
- Lenovo|联想将推出135W Type-C充电器:游戏本告别“砖头”
- 传统|联想预热 135W 充电器,新款拯救者笔记本有望支持 PD 3.1
- Apple|苹果希望手机/平板设备能正面为其他设备无线充电
- 协议|闪极发布 140W PD 3.1 充电器:2C1A 三口,首发 399 元
- 国际|第23届高交会线上线下共享科技盛宴
- 华为|华为正研究电动车充电设施,充7分钟电量可由20%到80%
- 影像|性能、视效、充电均属顶尖,全新iQOO 9 Pro再攀性能高峰
- 电子商务|无需扫码、碰一碰即可完成支付 数字人民币硬钱包充电桩项目启动!







